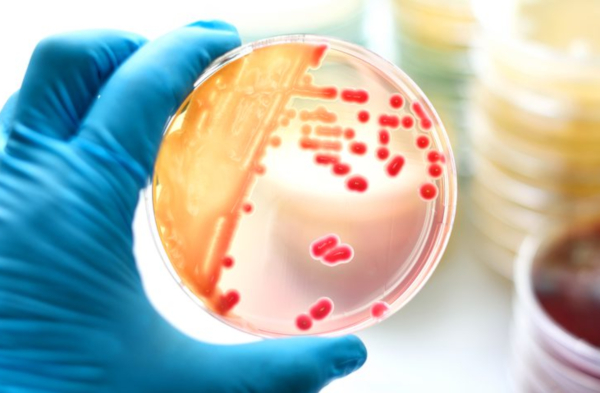
featured

naturalnootropic (25)
8 followers3 posts5 following0 HP
Blacklisted UsersMuted UsersFollowed BlacklistsFollowed Muted Lists
Blacklisted UsersMuted UsersFollowed BlacklistsFollowed Muted Lists
naturalnootropic.com Joined February 2019 Active 7 years ago